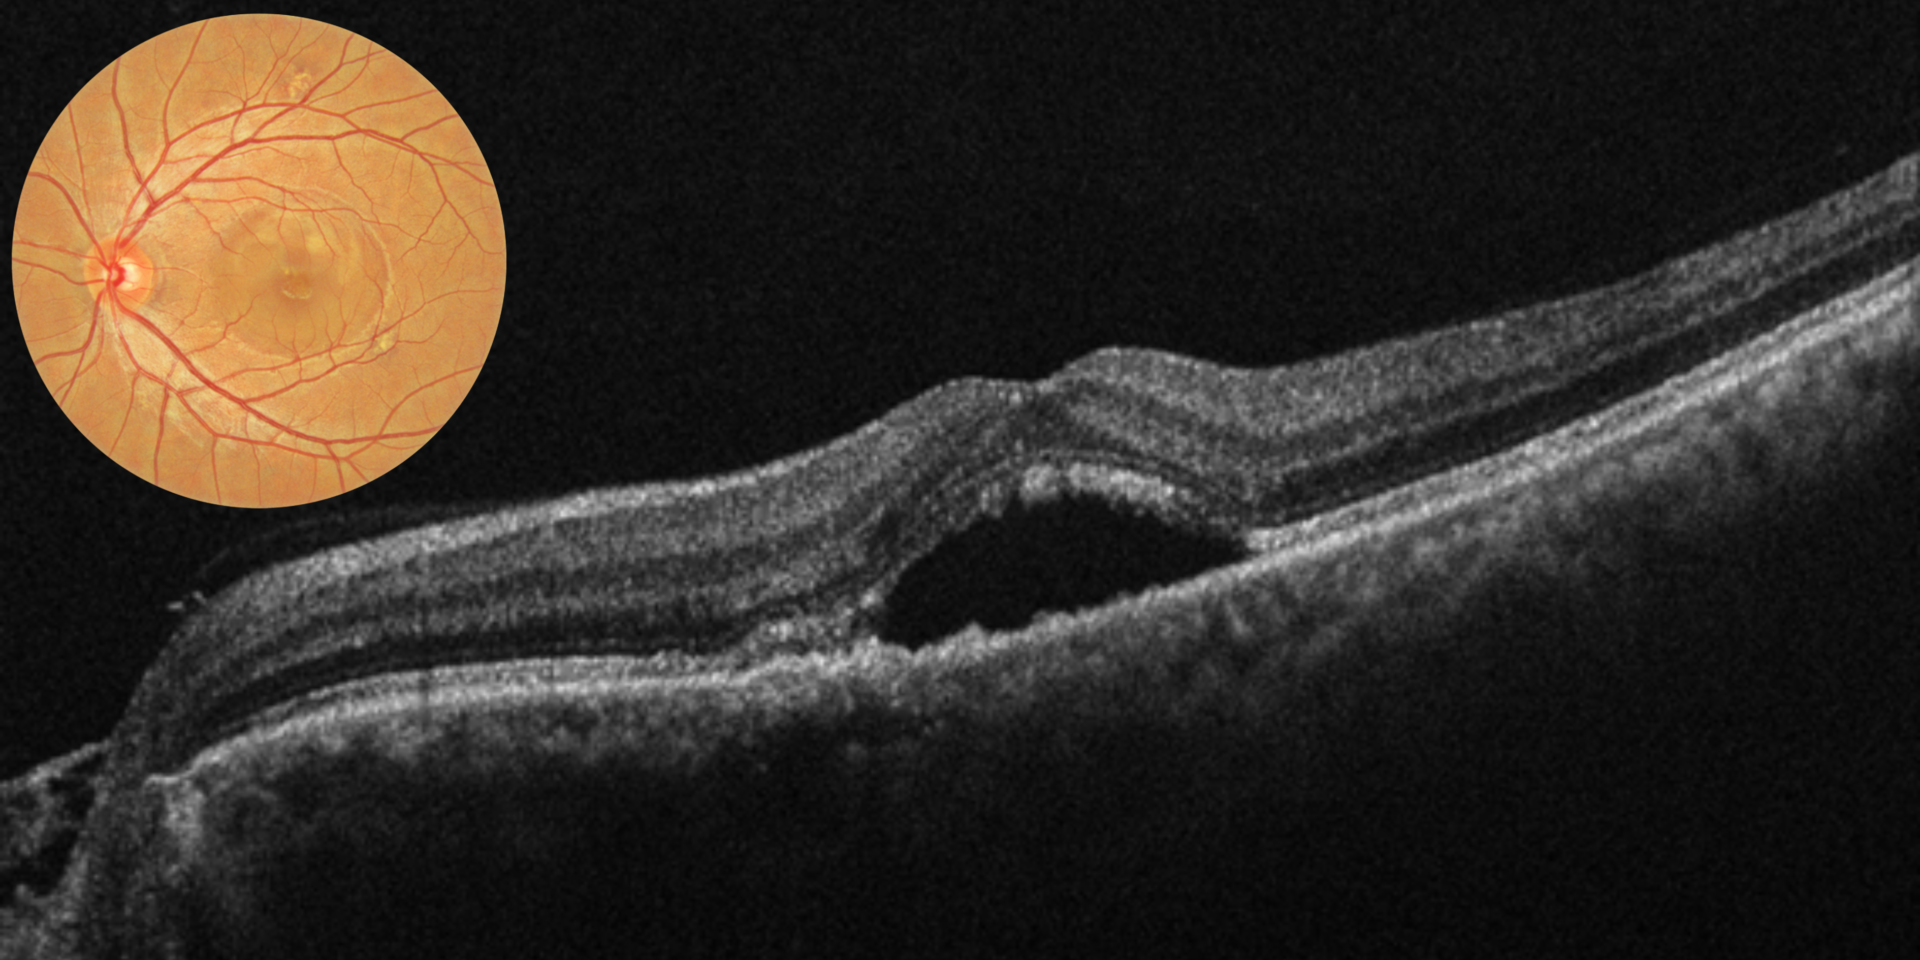

Retina & Uvea Services
At Dr. Haldar’s OrthoVision Healthcare, we provide advanced diagnosis and treatment for retinal and uveal diseases using state-of-the-art technology and evidence-based care. Our retina services are led by experienced specialists and are focused on early detection, precise treatment, and long-term vision preservation.
Retinal and uveal conditions often progress silently. Timely evaluation and treatment are crucial to prevent permanent vision loss.
What Are Retina & Uvea Disorders?
-
Retina is the light-sensitive layer at the back of the eye responsible for vision.
-
Uvea includes the iris, ciliary body, and choroid, which provide nourishment and immune regulation to the eye.
Diseases affecting these structures can cause blurred vision, floaters, flashes, eye pain, redness, or sudden vision loss.
Common Retina Conditions We Treat
Diabetic Retinopathy
Damage to retinal blood vessels due to diabetes.
-
Non-proliferative & proliferative diabetic retinopathy
-
Diabetic macular edema (DME)
Age-Related Macular Degeneration (ARMD)
-
Dry ARMD
-
Wet ARMD causing sudden central vision loss
Retinal Detachment
A sight-threatening emergency where the retina separates from underlying tissue.
Retinal Vein Occlusion (RVO)
-
Central retinal vein occlusion (CRVO)
-
Branch retinal vein occlusion (BRVO)
Retinal Artery Occlusion
Sudden, painless vision loss requiring urgent care.
Macular Disorders
-
Macular hole
-
Epiretinal membrane
-
Central serous chorioretinopathy (CSCR)
Floaters & Flashes
Often related to posterior vitreous detachment (PVD) or retinal tears.
Common Uvea & Uveitis Conditions We Treat
Uveitis (Eye Inflammation)
-
Anterior uveitis (iritis)
-
Intermediate uveitis
-
Posterior uveitis
-
Panuveitis
Infectious & Autoimmune Uveitis
Associated with tuberculosis, viral infections, rheumatoid arthritis, ankylosing spondylitis, and other systemic conditions.
Choroiditis & Vasculitis
Inflammatory conditions affecting deeper layers of the eye.
Advanced Diagnostic Services
We use high-precision imaging and tests for accurate diagnosis:
-
Optical Coherence Tomography (OCT)
-
Fundus Photography
-
Fundus Fluorescein Angiography (FFA)
-
Indocyanine Green Angiography (ICG)
-
Ultrasound B-scan
-
Visual Acuity & Retinal Function Tests
-
Systemic evaluation in collaboration with physicians when required
Retina & Uvea Treatment Options Available
Medical Treatments
-
Intravitreal anti-VEGF injections
-
Intravitreal steroid injections & implants
-
Oral and topical anti-inflammatory medications
-
Immunosuppressive therapy for uveitis
-
Antiviral, antibiotic, or anti-tubercular therapy (when indicated)
Laser Treatments
-
Retinal laser photocoagulation for diabetic retinopathy
-
Focal & grid laser for macular edema
-
Laser treatment for retinal tears
Surgical Management
-
Vitrectomy surgery
-
Retinal detachment repair
-
Management of complex vitreoretinal disorders
Why Choose Dr. Haldar’s OrthoVision Healthcare?
-
✔ Advanced retina & uvea care under one roof
-
✔ Modern diagnostic and treatment technology
-
✔ Personalized treatment plans
-
✔ Integrated care for diabetes-related eye diseases
-
✔ Trusted eye care center in Noida
When Should You See a Retina Specialist?
Seek immediate consultation if you experience:
-
Sudden vision loss or blurring
-
Flashes of light or increase in floaters
-
Distorted or wavy vision
-
Eye pain with redness
-
Vision problems related to diabetes or high blood pressure
Book a Retina & Uvea Consultation in Noida
Protect your vision with early diagnosis and expert care.
Schedule an appointment today at Dr. Haldar’s OrthoVision Healthcare, Noida for comprehensive retina and uvea services.

Dr. Sridevi Haldar
MBBS, DNB, FCRS
Cataract, Cornea & Refractive Eye Surgeon
Ex. Dr.Shroff Charity Eye Hospital
Ex. Aravind Eye Hospital, Madurai
Dr. Sridevi Haldar (Gunda) is an eminent eye surgeon providing expert services to leading city hospitals across Delhi NCR. She has been associated with Dr. Shroff Eye Hospital, Delhi; Venu Eye Institute, Saket and Sharpsight Centre in the past.
Qualification: After graduating in year 2005, she pursued her interest of specializing in the field of Ophthalmology and completed her post-graduation from world renowned, prestigious eye institute;”Aravind Eye Hospital & Post graduate Institute of Ophthalmology”, Madurai also popularly known as the’ Temple Of Eye’. Not only did she acquire skills to treat a disease but values of holistic and compassionate approach were imbibed in her. Carrying the vision to eliminate needless blindness, she has served across various reputed institutes across the country. She further pursued her interest in speciality of Cornea and Refractive surgery and was awarded fellowship degree after serving for 2 years at Dr. Shroff Eye Hospital, Daryaganj in department of Cornea and Refractive surgery. She has numerous national and international presentations to her acclaim.